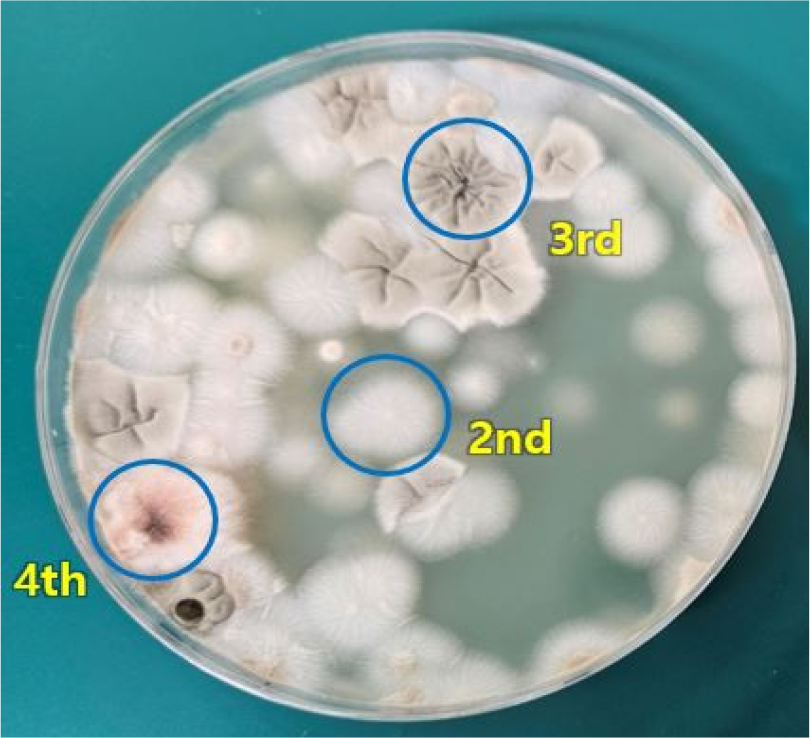
https://cdn.apub.kr/journalsite/sites/jkspe/2025-029-04/N0580290405/images/kspe_2025_294_039_F4.jpg

1. 서 론
2. 슬러지 샘플 채취 및 구성물질 추정
2.1 동력공급장비 내 슬러지 샘플 채취
2.2 슬러지 샘플 구성물질 추정
3. 슬러지 샘플 검사
3.1 슬러지 샘플 검사 개요
3.2 SEM-EDS 검사 결과
3.3 미생물 한도시험 및 동정시험 결과
3.4 적외선 분광 분석 시험 결과
4. 미생물 오염 대응 방안
4.1 자유수 정기 제거
4.2 파티클 필터 및 수분 필터 적용
4.3 살생제 투입
4.4 연료탱크 세척
4.5 연료유 교체
5. 결 론
1. 서 론
한국형발사체 1단 및 2단 연료-유압식 추력벡터제어 구동장치시스템은 발사체 연료로 사용되는 케로신을 유압 작동유로 활용한다[1,2]. 구동장치시스템 지상시험 운용에도 케로신이 사용됨에 따라 연료로 유압을 생성하여 구동장치시스템에 공급하는 동력공급장비의 연료탱크에는 케로신이 장기간 보관되는 상황이 발생한다. 연료탱크 내 케로신 보관 시 청정도를 관리하기 위하여 동력공급장비에는 수분제거기가 키드니 루프 방식으로 설치되어 있으며, 유압 공급라인에는 고성능 유압필터가 배치되어 있다.
케로신을 연료탱크에 장기 보관하는 경우 수분 및 기타 오염 물질의 유입으로 인해 연료 내에 미생물이 서식할 수 있다는 사실이 항공업계에 널리 알려져 있다[3,4,5,6,7,8,9,10]. 이러한 미생물은 케로신의 탄화수소를 분해하거나 황을 환원시키며, 대사 부산물로써 점액질의 바이오 필름을 생성할 뿐 아니라 기계 부품 등을 부식시킬 수 있다는 사실도 연구되어 왔다[11,12]. 점액질의 바이오 필름은 금속이나 고무 부식 외에도 그 자체가 이물질로 작용하여 민감한 유압 부품의 오작동을 일으킬 수 있다고 판단된다.
2024년 수행된 연료-유압 동력공급장비 유지보수 과정에서 연료탱크의 바닥면과 벽면에 겔 형태로 퇴적되어 있는 진갈색의 슬러지가 다량 발견되었다. 슬러지의 구성물질은 케로신 내 미생물 대사 부산물이거나 기타 유압 구성품에서 발생한 이물질 중 하나일 것으로 추정되었다. 해당 슬러지 샘플을 약 35 mL 채취하여 국내 공인시험기관을 통하여 화학 조성 분석 및 미생물 검사 등을 수행하였다.
본 논문은 슬러지 샘플에 대한 미생물 검사 결과를 기술한다. 수행된 검사는 전자현미경 촬영 및 X-ray 분광 분석(SEM-EDS), 미생물 한도시험, 세균 검출시험, 진균 동정시험, 적외선 분광 분석(FT-IR or Fourier Transform InfraRed spectroscopy)을 포함한다. 슬러지의 진균 동정시험 결과 케로신 곰팡이로 널리 알려져 있는 Hormoconis resinae가 검출되었으며, 적외선 분광 분석 결과 미생물 대사 부산물인 바이오 필름 성분이 포함된 것으로 판단된다.
마지막으로 일련의 검사 결과 및 해외 문헌 조사를 바탕으로 케로신 내 미생물 오염 예방을 위한 방안을 몇 가지 제시하였다. 관련 시스템 운용 환경 및 절차를 고려하여 현장에 적용할 수 있는 방안을 적극 채택하는 것이 바람직할 것으로 생각된다.
2. 슬러지 샘플 채취 및 구성물질 추정
2.1 동력공급장비 내 슬러지 샘플 채취
구동장치시스템의 지상시험을 위한 연료-유압 동력공급장비의 유지보수 작업이 2024년에 수행되었다. 연료탱크의 상단 커버를 탈거하고 내부를 확인한 결과 Fig. 1과 같이 연료탱크 바닥 및 벽면에 겔 형태의 슬러지가 퇴적된 것이 발견되었다. 바닥 및 벽면으로부터 슬러지를 채취하여 Fig. 2와 같이 Superclean 등급 유리병에 보관하였다. 슬러지 샘플의 총 용적은 약 35 mL 수준으로 확인되었다.
2.2 슬러지 샘플 구성물질 추정
슬러지 샘플의 구성물질은 세 가지 중 하나인 것으로 추정된다. 첫째는 HUM에 의한 대사 부산물인 것으로 추정되었다. 항공유에 서식하는 대표적인 HUM은 Pseudomonas aeruginosa(녹농균)와 같은 세균류, Hormoconis resinae와 같은 진균류가 있다. 이러한 세균 및 진균 대사 부산물은 점액질 형태를 띄며 연료탱크 벽면이나 바닥면에 퇴적될 수 있는 것으로 생각되었다. 둘째로는 Sulfate Reducing Bacteria(SRB)와 같은 특수한 세균류에 의한 대사 부산물인 것으로 추정되었다. 해당 세균류도 hydrocarbon을 환원시킬 수 있으므로 HUM으로 분류될 수 있으나 본 건을 다른 가설로 분류한 이유는 케로신(Jet A-1)이 황 함량이 높은 특성을 갖고 있기 때문이다. 만일 슬러지 샘플에서 SRB에 속하는 주요 세균류만 검출되는 경우라면 Jet A-1의 높은 황 함량이 슬러지 발생의 주요 원인일 수 있다. 셋째는 연료탱크와 연계된 유압 구성품에서 발생할 수 있는 기타 이물질일 가능성이다. 일례로 동력 발생을 위한 유압 펌프에 포함된 윤활유가 누유되어 연료탱크에 퇴적되었을 가능성도 생각할 수 있다. 이러한 추측은 샘플에 대한 화학적 조성 분석을 통해 상세 검토될 수 있을 것으로 판단된다.
3. 슬러지 샘플 검사
3.1 슬러지 샘플 검사 개요
슬러지 샘플의 구성물질을 상세히 파악하고 향후 이러한 종류의 오염을 예방하기 위하여 Table 1과 같이 물리학적, 생물학적, 화학적으로 다층적인 검사를 수행하였다.
Table 1.
Physical, biological, and chemical tests on the sludge samples.
| Test | Purpose | Remark |
| SEM-EDS |
Visual inspection, X-ray spectroscopy | Physical |
| MLT | Microbial quantification | Biological |
| MIT | Microbial identification | |
| FT-IR | Infrared spectroscopy | Chemical |
우선 전자현미경 검사(SEM-EDS or Scanning Electron Microscope - Energy Dispersive X-ray Spectroscopy)는 전자현미경으로 슬러지 샘플을 조사하여 샘플 표면의 형상을 관찰할 수 있게 해준다. 이 때 시료에 입사하는 전자로부터 발생하는 X-ray를 분광 분석하면 시료 표면의 원소별 중량비를 정량적으로 측정할 수 있다. 본 검사를 통해 슬러지 샘플의 형상 및 원소 조성비를 확인할 수 있다.
미생물 한도시험(Microbial Limit Test, MLT)은 슬러지 샘플을 별도의 배지를 통해 배양한 후 총 호기성 미생물수와 총 진균수를 확인하는 시험이다. 이 시험을 통해서는 슬러지 샘플 내에 미생물이 존재하는지 여부를 알 수 있으며, 집락형성단위(Colony-forming Unit, CFU)로 정량화한 수치와 시험자의 육안 검사를 통해 샘플 내에 세균과 진균 중 어느 미생물이 주로 존재하는지 판단할 수 있다.
다음으로 미생물 동정시험(Microbial Identification Test, MIT)은 주어진 샘플로부터 세균 혹은 박테리아를 배양 및 채취한 후 DNA 염기서열을 분석하고 미생물 라이브러리와 비교하여 특정 미생물이 존재하는지 여부를 결정하는 시험이다. 의뢰자(KARI)는 시험기관 측에 총 네 종류의 미생물 동정시험을 요청하였다. 검사 대상 미생물은 항공용 연료인 케로신 내에 서식하며 Microbially Induced Corrosion(MIC) 등을 유발하는 미생물 중 주요 세균 종으로 알려진 Pseudomonas aeruginosa(녹농균)[11,12,13]과 주요 진균 종으로 조사되는 Hormoconis resinae 및 Fusarium 계열[11,12]로 선정하였다.
마지막으로 적외선 분광 분석(FT-IR)은 X-ray보다 파장이 긴 적외선을 활용하므로 시료의 원소가 아닌 고분자 구조를 상세 분석할 수 있다. 따라서 샘플 내 미생물 서식 여부가 아닌 샘플 자체의 정체에 대한 심도 있는 분석이 가능하다. 검사 원리는 샘플 내 유기물 등에 의한 적외선 에너지 흡수를 스펙트럼으로 분석하고 결과를 화합물 라이브러리와 비교하여 샘플 내 화합물 종류를 특정하는 것이다. 이를 통해 슬러지 샘플이 어떤 화합물인지 후보 물질을 나열하고 상세 검토할 수 있다.
3.2 SEM-EDS 검사 결과
슬러지 샘플에 대한 전자현미경 검사 사진 및 해당 위치에서의 X-ray 분광 분석을 수행한 결과는 Fig. 3과 같다. 약 600 μm 크기로 확대된 슬러지 샘플 사진을 통해서는 시료의 표면이 물리적으로 균일하지 않다는 것을 확인할 수 있다. 해당 표시 영역에 대한 X-ray 에너지 스펙트럼 분석 결과 중량비를 가장 많이 차지하는 두 원소는 탄소와 산소로 각각 44.8%, 38.4%를 나타내고 있다. 이어서 아연 12.0%, 나트륨 1.7%, 구리 1.5%, 칼슘 0.5%, 철 0.4%, 마그네슘 0.3%, 황 0.2%, 인 0.1%의 조성 비율로 원소가 분포하는 것을 확인하였다. SEM-EDS를 통한 X-ray 분광 분석을 통해서는 샘플에 포함되어 있는 주요 원소의 조성을 확인할 수 있다. 이는 고에너지 X-ray에 기반한 짧은 파장을 활용하였기 때문이다. 그러나 샘플의 정체를 상세하게 확인하기 위해서는 원소 조성이 아니라 분자 구조를 파악할 필요가 있다고 판단되었다. 분자 구조를 파악하기 위해서는 X-ray가 아닌 IR(InfraRed)을 활용한 분광 분석을 수행하여야 한다. FT-IR을 수행할 경우 본 샘플의 화학적 조성을 더 구체적으로 분석할 수 있을 것으로 판단하였다.
3.3 미생물 한도시험 및 동정시험 결과
슬러지 샘플 10 g을 검체로 설정하고 샘플 내 미생물을 배양 및 균질화하여 미생물수를 CFU/g 단위로 검출한 1차 시험 결과는 Table 2에 정리하였다. 총 호기성 미생물수는 2.7 × 105 로 확인되며, 총 진균수는 1.1 × 106 으로 확인된다. 검사자의 의견에 따르면 총 진균수가 상당히 많아서 총 호기성 미생물수에도 데이터 왜곡을 주었을 가능성이 있다고 파악되었다. 본 시험을 통해서는 슬러지 샘플 내에 서식하는 주요 미생물은 진균류(곰팡이류)일 가능성이 높다는 것을 알 수 있었다. 그러나 1차 시험 시 요청한 Pseudomonas aeruginosa 동정시험에서는 해당 균이 검출되지 않았다. 이는 샘플을 배양하여 증식된 집락이 녹농균이 아님을 의미한다.
Table 2.
Microbial limit and identification test result.
| Test | Remark | Total count or result | |||
| 1st | 2nd | 3rd | 4th | ||
| Aerobes | CFU/g | 2.7e5 | - | - | - |
| Fungi | 1.1e6 | 9.0e5 | - | - | |
|
Identi- fication |
Pseudo- monas sp. | X | - | - | - |
|
Hormo- conis sp. | - | O | O | - | |
| Fusarium sp. | - | - | - | O | |
이어서 2차 시험에서는 총 진균수를 9.0 × 105 까지 배양하여 특정 진균 Hormoconis resinae에 대한 동정시험을 수행하였다. 미생물 배양 결과는 Fig. 4와 같다. 배양된 미생물 집락 중 ‘2nd’로 표기된 집락이 가장 많은 비중을 차지하는 진균으로 판단되어 해당 균에 대해 동정검사를 수행하였다. 시험 결과는 ‘양성’으로 확인되었다. 이는 슬러지 샘플 내에 해당 진균이 서식하고 있음을 의미한다. Hormoconis resinae는 케로신 곰팡이(kerosene fungus)로 널리 알려진 종으로, 케로신 내에 서식하며 황이 아닌 탄화수소만을 대사에 활용하는 특징을 가지고 있다. 본 곰팡이가 슬러지 샘플에 존재할 경우 추후 황 성분이 저감된 케로신을 연료탱크에 장기보관하더라도 연료탱크 내에는 Hormoconis resinae가 서식할 수 있다는 점을 시사한다. 케로신에 서식하는 미생물과 그로 인한 대사 부산물은 서보밸브와 같은 민감한 유압 구성품의 노즐을 막거나 가동부에 퇴적되어 주변부를 부식시키거나 그 자체가 이물질로 작용하여 구동장치에 이상을 일으킬 수 있다.
미생물 동정시험 3차 및 4차 시험에서는 Fig. 4에서 확인되는 ‘3rd’ 및 ‘4th’ 집락을 대상으로 동정시험을 수행하였다. 각 동정시험 시 특정하고자 했던 진균은 각각 Hormoconis resinae 및 Fusarium sp.이다. 3차 시험의 경우 Fig. 4에서 두 번째로 많은 비중을 차지하는 ‘3rd’ 집락이 ‘2nd’ 집락과 동일한 진균 종임을 알 수 있었다. 4차 시험에서 특정된 진균은 Fusarium solani로 확인되었다. Videla에 따르면 Fusarium solani도 항공용 연료 저장 구성품인 연료탱크 내에 다량 존재할 수 있다[11].
3.4 적외선 분광 분석 시험 결과
FT-IR은 X-ray가 아닌 적외선을 통해 샘플의 분광 분석을 수행하므로 샘플의 고분자 구조를 상세하게 검토할 수 있다. 시험 시편은 액상 및 고상이 혼합된 슬러지 샘플을 크리스탈 플레이트로 얇게 덮어 준비한다. 시험을 통해 취득한 적외선 흡수 스펙트럼을 화합물 라이브러리와 비교하여 시편의 구성물질이 무엇인지 관련하여 후보 물질을 추정할 수 있다.
시험 결과는 Fig. 5 및 Table 3과 같다. 우선 Fig. 5(a)는 FT-IR 시험 결과를 나타낸다. X축은 적외선의 파수 값을 나타내며 Y축은 흡수 스펙트럼 계수를 나타낸다. X축을 파장 단위가 아니라 파수 단위로 표기하는 것은 적외선 에너지 크기를 분석하기에 더 편리하기 때문이다. 적외선 파수 범위를 참고하면 본 시험은 중간적외선 대역을 활용한 경우임을 알 수 있다. 참고로 650 cm-1 미만의 스펙트럼은 주로 무기물의 분석에 사용되는 것으로 알려져 있다. 따라서 케로신 및 미생물 대사 부산물 등 유기물이 관심 대상인 본 분석에서는 주어진 파수 대역에 대한 분석만으로 충분하다고 판단된다. Fig. 5(b)와 Table 3은 FT-IR 수행 결과를 화합물 라이브러리와 대조한 결과이다. 흡수 스펙트럼의 유사도를 바탕으로 match ratio를 계산하여 index 순서대로 후보 물질을 나열하였다. 이 중 index 0은 슬러지 샘플 자체의 시험 결과를 나타내며 index 1-10은 타 화합물 라이브러리의 흡수 스펙트럼이다. Fig. 5(a)에서 파란 색으로 표시된 대역 A, B는 Fig. 5(b)와 Table 3의 후보물질 리스트와 유사도가 높게 도출되는 영역이다. 반면 붉은 색으로 표시된 대역은 기타 화합물 라이브러리에서 발견되지 않는 슬러지 샘플만의 독특한 파수 대역으로 생각된다.
Table 3.
FT-IR library comparison table.
슬러지 샘플에 대한 적외선 흡수 스펙트럼 결과 및 라이브러리 대조 결과를 참고하면 가장 유사도가 높은 물질은 예상한대로 kerosene(index 1)이 도출되었다. 이는 슬러지 샘플이 케로신 연료 탱크에서 채취되면서 샘플 내 혼합된 액상의 케로신이 적외선을 흡수한 결과인 것으로 판단된다. 다음으로는 MOBIL Genrex(index 2)가 도출되었으며 이는 기계 장치의 윤활유 등으로 사용되는 펌프 오일과 같은 화합물을 나타낸다. 이 결과는 슬러지 샘플 내에 윤활유 등이 일부 포함되었을 수 있다는 점을 의미한다. 이어서 index 3-10까지의 결과는 석유 계열의 제품 등을 의미하는 상품명 등으로 생각되며 미생물과의 관련성은 낮은 것으로 판단된다.
본 시험에서 중요하게 분석해야 하는 내용은 유사도가 높은 후보물질 리스트가 아니라, 오히려 어느 화합물 후보과도 일치하지 않는 흡수 스펙트럼이다. 슬러지 샘플의 흡수 스펙트럼을 Fig. 5(b) 및 Table 3의 index 0에서 상세히 살펴보면 index 1-10에서는 확인되지 않는 독특한 흡수 대역이 있음을 확인할 수 있다. 이를 Fig. 5(a) 파수 대역에 붉은 영역으로 표기하면 첫째는 3,750 cm-1 ~ 3,000 cm-1에 넓게 분포한 대역 I, 둘째는 1,750 cm-1 ~ 1,500 cm-1에 좁게 분포한 대역 II, 마지막으로 1,000 cm-1 ~ 650 cm-1에 넓게 분포한 대역 III으로 파악된다. 확인된 대역 I, II, III은 슬러지 샘플의 고상 물질이 흡수하는 스펙트럼일 가능성이 높다. 이를 추가 검토하기 위해서 타 시험 결과 등을 상세 검토할 필요가 있다.
Fig. 6(a)는 본 논문에서 취급하는 슬러지 샘플과 매우 유사한 환경에서 장기보관된 케로신 용기의 벽면에서 채취한 고체 상태의 샘플이다. 해당 샘플은 기타 공인시험기관에 별도 의뢰하여 FT-IR 검사를 수행한 바 있다. 관련 흡수 스펙트럼 결과는 Fig. 6(b)와 같다. X축은 파수 값을 나타내며 Y축은 흡수 스펙트럼 계수를 나타낸다. Cheeseman의 바이오 필름에 관한 FT-IR 연구[14]에 근거하여 Fig. 6(b)의 파수 대역은 3,000 cm-1 ~ 2,800 cm-1 구간은 지방질, 1,750 cm-1 ~ 1,600 cm-1 구간은 단백질, 1,200 cm-1 미만 구간은 다당류에 해당하는 바이오 필름 성분을 의미하는 것으로 분석되었다. 이러한 연구 사례는 Fig. 5에서 붉은 영역으로 표기된 세 종류의 파수 대역을 검토하는데 활용될 수 있다.
슬러지 샘플의 FT-IR 결과를 나타내는 Fig. 5의 대역 II는 파수 범위가 1,750 cm-1 ~ 1,500 cm-1로 확인되며 이는 앞서 확인한 바와 같이 단백질로 구성된 바이오 필름 성분으로 판단된다. 대역 III은 파수 범위가 1,000 cm-1 ~ 650 cm-1로 나타나며, 다당류에 해당하는 바이오 필름 성분을 포함하는 것으로 추정된다.
Ahmady-Asbchin의 연구[15]에 따르면 미생물의 세포벽에서 수산기(-OH) 신축 진동이 발생하여 3,500 cm-1 ~ 3,200 cm-1의 파수 대역에서 넓은 범위의 적외선 흡수가 발생할 수 있음을 언급하고 있다. 이러한 결과를 참고하면 대역 I은 바이오 필름에 포함된 다량의 수산기로 인한 흡수 스펙트럼일 가능성이 있다.
종합하면 슬러지 샘플에 대한 FT-IR 시험을 통해 샘플 내 케로신 혹은 윤활유 성분 외에 미생물 대사 부산물인 바이오 필름 성분이 포함되었을 가능성이 매우 높은 것으로 판단된다. 다만 Fig. 5(a)의 흡수 스펙트럼 대역 I에 대해서는 추가적인 연구가 필요할 것으로 생각된다.
4. 미생물 오염 대응 방안
본 장에서는 Hill의 논문[16]을 바탕으로 연료탱크 내 미생물 성장 방지를 위한 실질적인 대응 방안을 요약한다.
4.1 자유수 정기 제거
항공유 연료탱크 내 미생물 성장을 억제하기 위해서는 탱크 내부에 포함된 자유수를 자주 제거해주는 방안이 최우선으로 고려되어야 한다. 연료탱크를 유압 사용부보다 높게 배치하고 바닥면을 경사지게 설계하여 탱크 최하단부에 설치된 배수 밸브를 개방하는 방식으로 자유수를 제거하는 것이 주로 권장되는 방법이다. 그 이유로는 자유수가 미생물 생성 조건으로 작용한다는 사실도 고려될 수 있으나, 미생물의 군집이 형성되더라도 미생물 군집은 자유수보다 밀도가 높으므로 경사진 탱크를 따라 탱크의 최하단부로 모인다는 특징도 고려된다. 따라서 연료탱크 경사 설계 및 자유수 배수 방안이 연료탱크 미생물 성장 방지를 위해 현장 시스템에 가장 먼저 고려되어야 한다.
4.2 파티클 필터 및 수분 필터 적용
연료탱크에 미크론 수준의 파티클 필터와 수분 제거 필터를 적용하여 연료를 순환시키면 발생한 미생물의 상당 부분을 여과할 수 있다. 비록 연료 유동의 전단부 내 미생물 개체수보다 후단부 내 미생물 개체수가 적어질 수는 있으나 미생물의 크기에 따라 후단부의 미생물 개체수가 여전히 많을 수 있으므로 이 방법은 지나치게 의존되어서는 안된다. 또한 이 방법의 지속적인 유효성 확보를 위해서는 주기적인 필터 점검과 엘리먼트 교체가 필요하며, 필터의 미생물 제거 기능은 현장 시험을 통해 효과가 검증되어야 한다.
4.3 살생제 투입
항공용 연료에 사용될 수 있는 살생제는 여러 제약으로 인해 그 종류가 매우 제한되어 있다. 주요 제약조건으로는 살생제의 연소성이나 인화점 특성을 고려한 엔진 수락조건 등이 있다. Hill의 논문[16]에서는 FSII formulations와 IATA guidance를 인용하며 Jet A-1 연료에 대한 살생제로 Di-ethylene Glycol Mono-methyl Ether(DEGME)를 언급한다. 연료 첨가 용량은 0.15 ~ 2.00% 이다.
이어서 항공기 연료에 적용될 수 있는 살생제로 Biobor JF와 Kathon FP1.5가 소개된다. 두 제품은 각각 MIL-S- 53021 내 US Army Qualified Product List와 European BPD에 등록되어 있으며 모두 IATA에서 허용하고 있다. 다만 대상 연료에 따라 살생제의 특성, 투입 용량 및 엔진 수락조건 등을 상세하게 검토한 후 살생제 투입을 결정하여야 한다.
4.4 연료탱크 세척
연료탱크 내 수분 제거 및 살생제 투입 등으로 미생물 발생이 잘 예방되어 있다면 연료탱크의 세척은 필요하지 않을 수 있다. 그러나 연료탱크에 미생물이 발생하기 시작하면 정기적인 세척이 필요할 수 있다.
4.5 연료유 교체
Hill의 논문[16]과 별개로 미생물 성장을 예방하기 위해 한국형발사체 연료-유압 동력공급장비 연료탱크 내 연료유 전체를 정기적으로 교체하는 방법도 효과적일 수 있다. 자유수 정기 제거 및 수분 필터 적용 방법은 연료 내 자유수를 제거할 수는 있으나 수분 포화도를 저감하는 데는 한계가 있다. 따라서 지상시험에 사용되는 연료유에 미생물이 서식하기 전 연료탱크 내 연료유를 전량 교체하는 방법이 고려될 수 있다. 적절한 연료유 교체 기간 선정을 위해서는 기존 연료유의 채취 및 수분 포화도 측정 데이터 검토가 선행되어야 한다. 연료유 교체 시 연료탱크 세척 및 건조도 함께 적용될 수 있다.
종합하면 연료탱크 내 미생물 성장 방지를 위해서는 자유수 정기 제거, 파티클 및 수분 필터 적용, 살생제 투입, 연료탱크 세척, 연료유 교체 등의 방법이 있다. 이 외에도 유압 시스템 내 연료를 입자 계수기로 검사하고 청정도 등급을 SAE AS4059 규격으로 평가하여 연료탱크의 상태를 지속적으로 모니터링하는 방법도 권장된다.
5. 결 론
본 문서는 연료-유압 동력공급장비 유지보수 과정 중 연료탱크 내에서 채취한 슬러지 샘플에 대한 미생물 검사 결과를 기술하였다. 슬러지 샘플에서는 케로신 곰팡이로 널리 알려져 있는 Hormoconis resinae가 검출되었으며, 미생물 대사 부산물인 바이오 필름 성분도 포함된 것으로 판단된다. 해당 진균 종은 Sulfate Reducing Bacteria(SRB)가 아니므로 케로신에 포함된 황 성분과 무관하게 항공기 연료 내에 서식하며 부산물을 생성할 수 있다. 연료탱크 내 미생물이 발생하는 경우 미생물 대사 부산물이 발생하여 연료의 열화 및 소재의 부식 등이 유발될 수 있을 뿐 아니라 그 자체가 이물질로 작용하여 민감한 유압 부품의 오작동을 일으킬 수 있다고 판단된다. 따라서 미생물 발생에 대한 대응 방안이 마련되어야 한다. 이에 본 논문은 해외 문헌에서 확인되는 미생물 발생 대응 방안으로 자유수 제거, 파티클 및 수분 필터 적용, 살생제 적용, 연료탱크 세척을 다루었다. 이 중 연료탱크 경사 설계를 통한 자유수 정기 배수와 파티클 및 수분 필터 적용 방안은 현장의 시스템 운용 환경 및 절차를 고려하여 현장에 적극 채택하는 것이 바람직할 것으로 판단된다. 연료 내 살생제 적용과 연료탱크 세척 방안은 유관부서와의 협의 및 연료탱크의 상태 점검 등을 통하여 추가 적용이 검토될 수 있을 것으로 생각된다. 더불어 한국형발사체 지상시험을 위한 연료-유압 동력공급장비 운용 환경에서는 연료 내 미생물이 서식하기 전에 일정 기간 이상 사용된 연료유 전량을 주기적으로 교체하는 방법도 함께 검토될 수 있다.